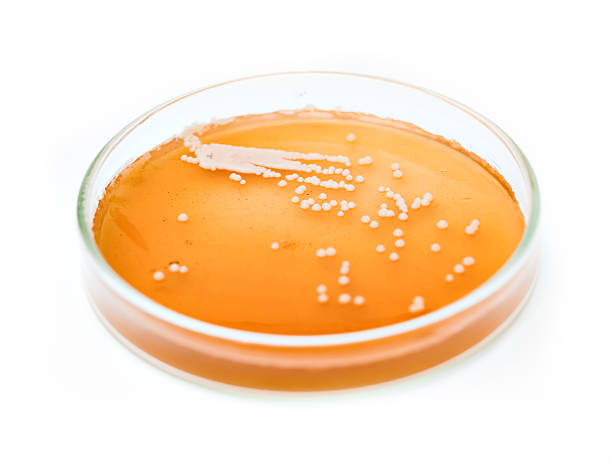

맥주효모는 맥즙의 발효물로 탈모개선에 도움이 있다고 하여 알아보겠습니다. 맥주효모에
눈영양분이 많이 함유되어 있다고 하여 예전부터 다양하게 사용되고 있었습니다. 비타민
과 각종미네랄이 품부 하여 우리 몸에는 적합 것으로 되어 있다.

맥주효모란?

- 맥주효모는 맥주를 만들 때 발생하는 미생물 식품으로 맥주를 제조하는 과정 중에 만들어지는 효
모를 건조한 것을 말합니다.
- 겉보리의 낟알 맥아를 익혀 만든 맥즙의 발효가 끝나면 액체와 고체가 위아래층으로
나누어져 있는데 위에 떠있는 것은 맥주이고 아래층에 고체는 맥주효모입니다. 비타민 B와 각종
미네랄을 함유하고 있는 것으로 우리들에게 많은 도움을 주고 있다.
- 맥주효모는 맥주효모균사체이고 효모균은 맥주를 만드는 과정에서 넣는 균입니다.
- 균을 배양하여 일부는 맥주로 사용하고 남는 부산물은 건조해 섭취하는 것이 맥주 효
모입니다.
- 맥주를 배양하는 과정에서 맥주효모균이 보리 맥아에 있는 영양소를 섭취하고 그것
을 대사 시켜가지고 자기 몸에 여러 가지 유익한 성부로 전환시켜서 저장을 합니다.
맥주효모의 영양성분.
- 비타민 B군 성분 중에서 B5, B6는 멕주효모균에 사 발견한 것입니다. 종합비타민으로
활용할 수 있을 정도의 용량이 들어있다. 100g에 1mg 내외 비타민 B2, B5가 들어 있다고
합니다
- 맥주효모에서 추출한 셀레늄이 많이 함유하고 있다.
- 양질의 셀레늄과 크롬을 함유하고 있어서 우리 몸에 황산화역할과 인슐린 저항성을 개
선시키는 목적으로 활용하고 있다.
- 비타민 B군 영양제에는 맥주효모 추출물 포함으로 많이 되어 있다.
- 맥주 효모에는 단백질이 풍부해 모발에도 도움을 구고 있다.
- 효모 유래한 베타글루칸도 함유하고 있다.
![]() |
![]() |
![]() |
맥주효모 활용.
- 맥주효모에는 다양한 성분들이 사람의 두피와 모발 건강에 도움을 주고 있는 것으로 알려져 있다
- 비타민B군, 미네랄 일부, 단백질 등이 포함되어 있어 종합영양제로 사용할 수가 있습니다.
- 셀레늄과 크롬이 함유되어 있어서 성인병에 적극적으로 활용할 수사 있습니다.
- 단백질과 셀레늄 같은 황산화 성분을 함유하고 있어서 모발 건강에도 좋을 수 있습니다.
- 손발톱이 깨지거나 모발이 푸석푸석하는 분 그리고 여성용 탈모에 활용할 수사 있습니다.
- 베타글루칸이 들어가 있기 때문에 고지혈증에도 활용할 수가 있고, 항균력이 뛰어나기 때문에
피부에 염증을 완화시키는데 도움이 됩니다.
- 만약에 두피나 피부에 염증이 있다면 맥주효모 성분이 들어간 샴푸나 비누를 사용하면 좋습니다.
- 아미노산을 합성하는 성분들이 많이 있기 때문에 두피와 모발에 필요한 영양소가 맞기 때문에 지
속적으로 섭취할 경우 두피와 모발이 건강하게 유지될 수가 있습니다.
- 면역밸런스를 잡는 데 활용할 수도 있습니다.
맥주효모 섭취용량.
- 맥주효모는 태블릿이 있고 떠먹는 파우더가 있습니다.
- 파우더가 적합하고 3g ~5 g 정도를 매일 섭취하고, 많게는 20 ~ 30g까지 사용한다는 데이터가
있습니다.
- 파우더의 맛은 비리고 시고 그럼 맛입니다.
맥주효모 주의사항.
- 탈모는 두피나 모발의 영양상태와는 별개로 사람의 그 DHT호르몬이 모근세포를 파괴해서 모발
의 생성능력이 떨어지기 때문에 발생하는 것이 탈모입니다.
- 그렇기 때문에 사람이 맥주효모를 지속적으로 섭취해서 우리의 모발에 영양 성분을 공급해 주더
라도 사람 몸속의 DHT호르몬이 모근계를 공격하면 탈모는 그대로 진행될 수밖에 없다는 것입니
다.
- 탈모가 진행될 때에는 병원에 가서 치료를 받아야 합니다.
- 맥주효모는 두피나 모발의 영양소 공급을 위해서 먹는 것입니다.
- 맥주효모에는 아미노산 덩어리이고 퓨린 같은 것들이 들어있어 통풍이 있는 분은 피해야 합니다.
- 외부물질이기 때문에 알레르기나 경미한 위장장애 또는 가스가 차는 증상이 있을 수 있습니다.
- 고혈압약이나 우울증 약을 복용하시는 분들은 주의해야 합니다.
- 모노아민 산화 효소 억제제를 복용하시는 분들은 맥주효 섭취를 피하는 것이 좋습니다.
![]() |
![]() |
※ 맥주효모는 두피나 모발의 영양소 공급용을 위해서 먹는 것입니다.
효모균의 발효 효능을 활용 !
효모는 인간과 오래전부터 함께 공생을 하고 있는 균종류에 속하는 미생물이다. 미생물로서 증식형태도 어떤 생물과도 다른 독특한 방식으로 생존한다. 자낭균강에 속하는 효모는 일반적으로
69naturalmarket.com